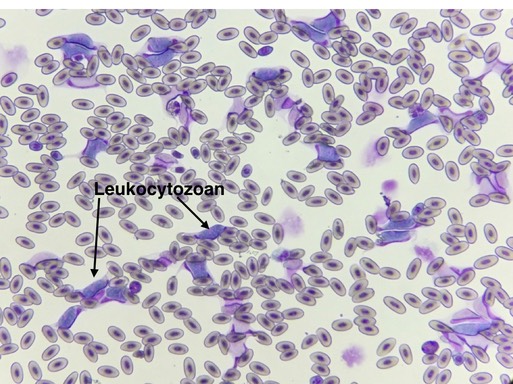
Leukocytozoan.001

Interns Todd and Zabrina are Working Long Hours
Below the interns are giving oral fluids to an emaciated fledgling Red-tailed Hawk.

If business keeps up at its current pace, by the end of June, we will have admitted as many birds as we did in all of 2017 (970 birds between the Pendleton and Tri-Cities centers).
Great Horned Owl 18-260
Volunteers Tim and Liz Quigg transported a fledgling Great Horned Owl from Dayton to Pendleton. The young owl did not seem to sustain any injuries from being hit by a car, but she was emaciated with a huge load of a blood parasite, leukocytozoan. Unfortunately we were not able to save her.
Great Horned Owl 18-262
It was a rough week for Great Horned Owls. 18-262 arrived with a piece of barbed-wire fencing still attached to his wing. The wire caused too much damage to save the owl’s wing.

Swainson’s Hawk 18-266
The saddest case admitted this past week was a female Swainson’s Hawk who had been shot. The physical exam revealed she had a brood patch, indicating she was either incubating eggs, or young chicks (likely considering the time of year).

Coracoid fractures have about a 15% chance of healing well enough for the bird to be released whether the fracture is repaired surgically or the wing is immobilized with a bandage. We have chosen the latter method. It will be at least a month, and perhaps two, before we know if we will be successful. In the mean time, the young will very likely die.
Fledgling Western Screech Owls
The window will be opened and these two fledgling Western Screech Owls will be released this week. They will join seven other screech owls who have already been released and are still visiting a feeding platform to pick up a mouse as they learn to hunt.








